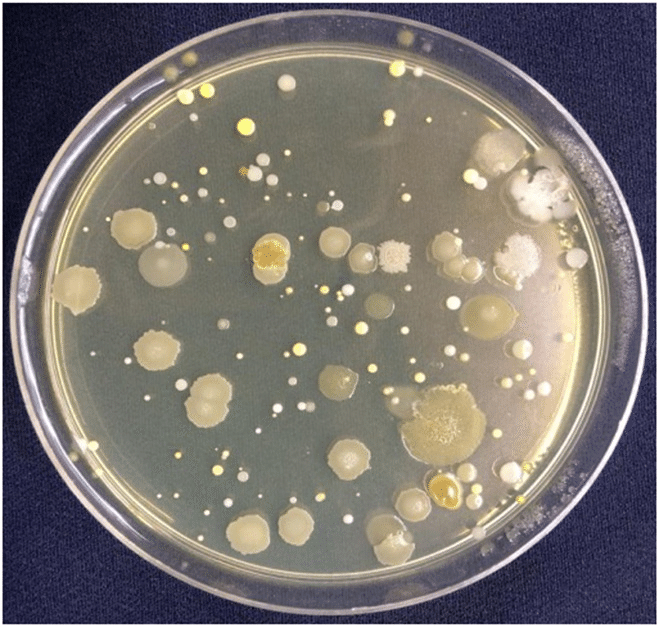

“எம்மா (Emma), நீ என்னைத் திருமணம் செய்து கொள்வாயா? உன்னைக் கப்பலில் பல இடங்களுக்கும் அழைத்துச் செல்வேன்,” மருத்துவனாகப் படிக்கும் ராபர்ட் கேட்டான். எம்மா புத்திசாலி. “இல்லை ராபர்ட், நீ ஓரிடத்தில் தங்கி ஒழுங்காக உன் படிப்புக்கேற்ற வேலை செய்வதானால் நான் உன்னை மணந்து கொள்வேன்.” எம்மா தான் ஜெயித்தாள். ராபர்ட்டின் காதல் அத்தனை வலுவானது. 24 வயதில் இருபது வயதான எம்மாவை மணந்தான் ராபர்ட். சில நூறு குடும்பங்களே இருந்த ஜெர்மானிய ஊர்களில் மருத்துவராக வேலை பார்த்தான்; பெண்கள் குழந்தைகளைப் பெற்றெடுக்க மருத்துவ உதவி செய்தான். வயதான தாத்தாக்களுக்கும் பாட்டிகளுக்கும் வைத்தியம் செய்தான். சுரத்தே இல்லாமல் தான் இவையனைத்தும் நடந்தன. கப்பலில் ஏறி இலக்கின்றிப் பயணித்துப் புது நாடுகளுக்குச் செல்ல வேண்டும் என்ற மனது கொள்ளாத ஆசை அவனுக்கு. நிறைவேறாத ஆசைகளைச் சுமந்துகொண்டு எவர்தானில்லை? ஆனால் நிலையான வருமானம்தானே குடும்பத்தைப் பராமரிக்க உதவும்?
எம்மா ராபர்ட்டின் மனதை அறிவாள். அவனுக்காக ஒரு அரிய பரிசை அவனது 28வது பிறந்தநாளன்று வழங்கினாள். அதுதான் ஒரு மைக்ரோஸ்கோப். ஐரோப்பாவின் அருமையான கண்டுபிடிப்பு. நோயாளிகளைப் பார்த்த நேரம்தவிர மற்ற நேரத்தை அந்த அருமையான கண்டுபிடிப்பை உபயோகிப்பதில் செலவழித்தார் ராபர்ட் காச் (Koch). 18ம் நூற்றாண்டில் விஞ்ஞானிகள் நோய்கள் எவ்வாறு உண்டாகின்றன என அறிந்துகொள்வதில் ஆர்வம் செலுத்தினர். ராபர்ட் காச் அதற்கு விதிவிலக்கல்ல. ஆந்த்ராக்ஸ் (Anthrax) எனும் ஒரு வியாதி (கொள்ளைநோய்) கால்நடைகளைப் பெருமளவில் அழித்து வந்தது. எல்லா ஆராய்ச்சியாளர்களும் அது எதனால் என அறிந்துகொள்ள ஆர்வம் காட்டினர். ‘நோய் நாடி நோய்முதல் நாடி,’ என்பதல்லவா முறை?
கையில் கிடைத்தவற்றையெல்லாம் மைக்ரோஸ்கோப்பில் பார்க்கும் ஆர்வம் உண்டு ஆராய்ச்சியாளர்களுக்கு. காச்சின் அடிமனதில் ஒரு எண்ணம். இந்த வியாதிகள் எல்லாவற்றிற்கும் காரணம் நுண்ணுயிரிகளே என்று. ஏனென்றால் ஒட்டுவாரொட்டியாக ஆந்த்ராக்ஸ் நோய் கால்நடைகளை அழித்து வந்தது. முதலில் ஒரு ஆடோ, மாடோ, பின் இரண்டு, மூன்று, நான்கு என மந்தையின் பெரும்பகுதி இறந்து அழியும். மனிதர்களையும் இந்நோய் விட்டுவைக்கவில்லை. எப்படி அதை நிரூபிப்பது? ஒருநாள்……
தனது மைக்ரோஸ்கோப்பில் ஆந்த்ராக்ஸால் இறந்துபோன சில ஆடுமாடுகளின் இரத்தத் துளிகளை ‘ஸ்லைட்’ (Slide) எனப்படும் கண்ணாடித் துண்டுகளின்மீது பரப்பி, அவற்றை மைக்ரோஸ்கோப்பில் பார்வையிடலானார் காச். சிவப்பு இரத்த அணுக்களின் இடையே அதென்ன கட்டுக்கட்டாகக் குச்சிகள் போலக் காண்கின்றன? நோய்வாய்ப்படாத மாட்டின் ரத்தத்தில் இந்தச் சிறு குச்சிகள் இல்லை! சொல்லிவைத்ததுபோல நோய்வாய்ப்பட்ட அத்தனை மிருகங்களின் ரத்தத்திலும் அவை காணப்பட்டன. இவைதான் நோய்க்குக் காரணமோ? இதனை எப்படி நிரூபிப்பது?
சில பரிசோதனை வெள்ளெலிகளை எடுத்துக் கொண்டு அவற்றிற்கு இந்த குச்சிகள் இருக்கும் இரத்தத்தைச் செலுத்தினார். சில எலிகள் குச்சிகள் இல்லாத இரத்தத்தைப் பெற்றன. ஆச்சரியம். அடுத்தநாள் காலை குச்சிகள் இருக்கும் ரத்தம் செலுத்தப்பட்ட எலிகள் அனைத்தும் இறந்திருந்தன. திரும்ப இதே பரிசோதனையைச் செய்தார். திரும்ப அதே முடிவுகள். உள்ளம் துள்ளிக் குதித்தது. இந்தக் குச்சி போன்றவைகள் ஒருவிதமான நுண்ணுயிரிகள் என முடிவு செய்தார்.
ஒரு நாள் மாலை…. பரிசோதனைகளைத் தொடர, சில ஸ்லைடுகளை மைக்ரோஸ்கோப்பின் அடியில் பார்க்க முற்பட்டார். அப்போதுதான் வாசற்கதவு தட்டப்பட்டது. மிகவும் சீரியஸான ஒரு நோயாளியை அவர் உடனேசென்று பார்க்க வேண்டியிருந்தது. சென்று, பார்த்து, மருந்துகொடுத்துவிட்டு, வீடுதிரும்ப வெகுநாழியாகி விட்டது. வீட்டினுள் நுழைந்தததும் தான் தனது ஸ்லைடுகளைப் பற்றிய ஞாபகம் வரவே, உடனே அங்கு சென்றார். எல்லாம் காய்ந்து உலர்ந்து போயிருந்தன. என்ன செய்யலாம் என யோசித்தவர், கசாப்புக்கடையிலிருந்து மிருகங்களின் உடல் திரவங்களைச் (Body fluids) சிறிது வாங்கிவந்து அவற்றைக் காய்ந்த ஸ்லைடுகளில் கவனமாகச் சேர்த்தார். பின் பார்த்தபோது, அந்தக் குச்சி நுண்ணுயிரிகள் காணாமல் போயிருந்தன. எங்கே போய்விட்டன? இப்போது புதியதாகப் பல பளபளப்பான முட்டைவடிவ மின்னும் அமைப்புகள் நிறையக் காணப்பட்டன. குச்சிகள்தாம் இவ்வாறு மாறிவிட்டனவோ? எப்படி இதனை நிரூபிப்பது?
இவற்றை எடுத்து இப்போது எலிகளுக்குள் ஊசியால் செலுத்தினார். அடுத்தநாள் காலை வழக்கம்போல அவை இறந்திருந்தன. அவற்றின் ரத்தத்தை ஆய்ந்தபோது குச்சிவடிவ நுண்ணுயிரிகள் காணப்பட்டன. அவை ரத்தம் காய்ந்துவிட்டபோது (சூழ்நிலை தங்களுக்கு அனுகூலமாக இல்லாதபோது) மின்னும் முட்டைவடிவங்களாக மாறின. இவற்றைப் பிற்காலத்தில் ஆராய்ச்சியாளர்கள் ‘ஸ்போர்’கள் (spores) எனக் குறிப்பிட்டனர். (ஜனவரி 2023 குவிகம் இதழில் எனது கட்டுரையில் இவை பற்றிய விளக்கத்தைக் காணலாம்) இந்தப் பரிசோதனைகளைப் பலமுறைகள் செய்துபார்த்தபின்பே ராபர்ட் காச் தமது முடிவுகளை உலகத்தாருடன் பகிர்ந்துகொண்டார்.
இதுவே நுண்ணுயிரிகள் நோயுடன் தொடர்பு கொண்டவை எனும் முதன்முதல் கண்டுபிடிப்பு. இவையே ‘காச்சின் அடிப்படை நிபந்தனைகள்’ (Koch’s Postulates) எனக்கூறப்படுகின்றன. அக்காலத்தில் இது எத்தனை பெரிய கண்டுபிடிப்பு தெரியுமா? உலகையே புரட்டிப்போட்டது. ஒரு பயங்கர நோயின் காரணத்தைக் கண்டுபிடிப்பது சாமான்ய விஷயமா?
ஐரோப்பிய அமெரிக்கக் கண்டங்களின் ஆராய்ச்சியாளர்கள் நோய்களை உண்டாக்கும் நுண்ணுயிரிகளைக் கண்டுபிடிப்பதில் மும்முரமாக ஈடுபட்டனர்.
இன்னொரு பயங்கரமான வியாதி மனிதர்களைச் சாகடித்துக் கொண்டிருந்தது. அதுதான் காசநோய் என்னும் டி. பி. டியூபர்குலோஸிஸ் (Tuberculosis). முதலில் இந்த வியாதி இருப்பது பெருமையாகக் கருதப்பட்டது!! ஒரு வெள்ளைக் கைக்குட்டையை வைத்துக்கொண்டு இருமும்போது வாயை மூடிக்கொண்டு பின் அதில் சிவந்த இரத்தக்கறை இருப்பது ஒரு நாகரிகமாகக் கருதப்படடது!! ஆனால் இந்த நோய் உள்ளவர்கள் விரைவில் இறந்து விடுவதும் அவர்கள் குடும்பத்தோர் இந்த நோய்க்கு உள்ளாவதும் மக்களை அதிர்ச்சிக்குள்ளாக்கியது. ஆராய்ச்சியாளர்கள் இது பற்றிய ஆராய்ச்சியில் களமிறங்கினர்.
காச் தன் பங்கிற்குத் தானும் களமிறங்கினார். சிறிய உருவம் கொண்ட, அந்த சாதாரணமான மருத்துவர் தனது பங்களிப்பு, கண்டுபிடிப்பு என்னவென்று அப்போது அறிந்திருக்க சாத்தியமில்லை; தன்னடக்கம், ஒரே மனதான முனைப்பு, விடாமுயற்சி இவையே அவருடைய தாரக மந்திரம் ஆயிற்று.
டி. பி. ஒரு கொடூரமான தொற்றுநோய். உடனிருந்து கொல்லி. இந்த நோயினால் இறந்தவர்களின் நுரையீரல்களில் சிறு சிறு மஞ்சள்நிற முடிச்சுகள் போன்றிருக்கும். இவற்றை டியூபெர்க்கிள் (tubercle) என்பார்கள். காச் இவற்றைத் தமது மைக்ரோஸ்கோப்பில் பார்க்க முயன்றார். ஒரு நுண்ணுயிரியையும் அதில் காண முடியவில்லை. தனது ஆந்த்ராக்ஸ் முயற்சியிலிருந்து நுண்ணுயிரிகள் எந்த வடிவிலும் இருக்கலாம் என உணர்ந்திருந்தார் அவர். பலவிதமான சாயங்களால் (dyes) அவற்றிற்கு நிறமூட்டிப் பார்க்க முயன்றார். பல நாட்களுக்குப் பின் அவரால் கொத்துக் கொத்தான மெல்லிய குச்சிகளைப் போன்றவற்றைப் பார்க்க முடிந்தது. ஆந்த்ராக்ஸ் பாக்டீரியாவைவிட ஐந்துமடங்கு சிறியதாக இவை இருந்தன.
மேலும் கினிபிக் (guinea-pig) எனப்படும் சில சீமைப்பெருச்சாளிகளுக்கும் இவற்றை உடலில் செலுத்தியிருந்தார். அவை நோய்வாய்ப்படுகின்றனவா எனவும் தினம் கண்காணித்தார். சில உருளைக்கிழங்குகளைக் குறுக்கில்வெட்டி, (அவற்றில் ஏற்கெனவே அமர்ந்திருக்கும் பாக்டீரியாக்களைக் கொல்வதற்காக) வேகவைத்து பின் அவற்றில் இந்த டியூபெர்க்கிளைப் பரப்பி அவற்றை மனித உடலின் வெப்பத்திற்கேற்றபடி வைக்கப்பட்ட இன்குபேட்டர்களில் வைத்தார். வீட்டிலேயே இதற்காக ஒன்றை அவரே தயாரித்திருந்தார்!! ஒருநாள், இரண்டு, மூன்று, ஒன்றும் நடக்கவில்லை. நமது மருத்துவரோ விடாக்கண்டர். மிகுந்த பொறுமை காத்தார்.
கிட்டத்தட்ட 20 நாட்களின்பின், சீமைப்பெருச்சாளிகள், நோய்வாய்ப்பட்டன, அடுத்த சில தினங்களில் ஒவ்வொன்றாக இறந்தன. அவற்றின் நுரையீரல்களிலும் டியூபெர்க்கிளைப் பார்க்க முடிந்தது. உருளைக் கிழங்குகளிலும் வெண்ணைபோன்ற மென்மையான ஒன்று படர்ந்திருந்தது. மைக்ரோஸ்கோப்பில் பார்த்தபோது அவை அந்த டி.பி. பாக்டீரியாக்களே என அறிந்தார். பரிசோதனைகளைப் பலமுறை திரும்பத் திரும்பச் செய்து உறுதிப் படுத்திக் கொண்டார். ஆனால் ஒவ்வொரு முறையும் இப்பரிசோதனைகள் நீண்ட நாட்கள் எடுத்துக்கொண்டன. பிற்காலத்தில், பல ஆண்டுகளின்பின், பாக்டீரியாக்களின் வளர்ச்சியைப்பற்றி ஆராய்ந்தவர்கள் கண்டு கொண்டதென்ன? பல பாக்டீரியாக்கள் இருபது நிமிஷங்களில் ஒன்று இரண்டாகவும், இரண்டு நான்காகவும் ஆகிவிடும்போது டி.பி. பாக்டீரியா மட்டும் ஒன்று இரண்டாக 24 மணி நேரம் எடுத்துக் கொள்கிறது. இவை பல மில்லியன்களாக ஆகும்போது பாக்டீரியாக் காலனி (bacterial colony) என்ற வட்டமான ஒரு அமைப்பைத் தான் வளருமிடத்தில் உண்டாக்குகிறது.
சரி, இப்போது ராபர்ட் காச்சிடம் திரும்ப வரலாம். தனது அதிசயமான அற்புதமான கண்டுபிடிப்பை உலகிற்குத் தெரிவிக்க வேண்டாமா? மார்ச் 24ம் தேதி, 1882ம் வருடம். ஜெர்மனியின் பெர்லின் நகரில் முக்கியமான விஞ்ஞானிகளின் கூட்டம் நடைபெறப் போகின்றது. ஒரு அறையில் புகழ்வாய்ந்த பல விஞ்ஞானிகள் – பால் எர்லிஷ், (Paul Ehrlich) ருடால்ஃப் விர்ஷோ (Rudolph Virchow), இன்னும் பலர் குழுமியிருந்தனர். இவர்களுள் ருடால்ஃப் விர்ஷோ மற்றவர்களின் ஆராய்ச்சி முடிவுகளை எளிதில் ஏற்றுக் கொள்ளமாட்டார். “பாக்டீரியாக்கள் நோய்களுக்குக் காரணமா. என்ன பிதற்றல்,” என்று கூறிக்கொண்டிருந்தார் அவர்.
மீட்டிங் தொடங்கிற்று. தனது மூக்குக் கண்ணாடியைச் சரிசெய்து கொண்டு, கையிலிருந்து நழுவும் பேப்பர்களைப் பிடித்துக்கொண்டு எழுந்தார் ராபர்ட் காச். அவரை நோக்கி நக்கலும் அலட்சியமும் கலந்த பார்வையை வீசினார் விர்ஷோ. ஆனால் ராபர்ட் காச் தனது மெல்லிய, அழுத்தமான குரலில், முறையாகத் தான்செய்த பரிசோதனைகளை ஒன்றன்பின் ஒன்றாக நன்றாக விளக்கினார். நடுவில் யாரும் கேள்வி கேட்க வேண்டிய அவசியமே இல்லாமல் அவை அழகாக விளக்கப்பட்டன. எவ்வாறு தான் டி. பி. பாக்டீரியாக்களைக் கண்டறிந்தேன் என்று விவரித்தார். இவை எவ்வாறு வளரும், எப்படி மனித உடலில் ஒளிந்து கொள்ளும், எவ்வாறு தேடிக் கண்டுபிடிப்பது எனவெல்லாம் கூறக் கூற அனைவரும் மணிக்கணக்காக ஆவலுடன் அவர் கூறியனவற்றைக் கேட்டனர்.
பேச்சின் முடிவில் நன்றிகூறிவிட்டு காச் அமர்ந்தார். அடுத்தபடியாகக் கேள்விகளும் விவாதங்களும் தொடரும். ஆனால் பேச்சு மூச்சில்லை. ஒருவர் முகத்தை ஒருவர் பார்த்தனர். ருடால்ஃப் விர்ஷோ, அறிவியல் உலகின் முடிசூடா மன்னர், கூட வாய் பேசவில்லை. பல நிமிடங்களின்பின்பு அவர் எழுந்தார்; தன் தொப்பியைத் தலையிலணிந்துகொண்டு அறையைவிட்டு வெளியேறினார். அது அருமையான ஒரு ஆராய்ச்சிக்கு / கண்டுபிடிப்புக்கு அவர் தந்த மரியாதை.
ராபர்ட் காச்சின் புகழ் உலகெங்கும் பரவியது. நீண்டநாட்கள் கழித்து இந்த மார்ச் 24 ஐ, இந்தக் கண்டுபிடிப்பை கௌரவிக்கும் வண்ணம் உலக டி. பி. தினமாக அறிவித்தனர். வருடாவருடம் ஒரு இலக்கான வாக்கைக் (slogan) கொண்டு வரும் நாள் இது. இவ்வாண்டு “ஆம், நாம் டி.பி.யை ஒழித்து விடலாம்,” (Yes, we can end TB) என்பது அந்த சொற்றொடராகும்.
இந்தக் கட்டுரையை எழுதி உங்களுடன் பகிர்ந்து கொள்வதில் நான் பெரிதும் பெருமை கொள்கிறேன். ராபர்ட் காச் எனது அறிவியல் உலக ஹீரோ! என் ஆராய்ச்சிப் பணியின் பெரும்பான்மையான ஆண்டுகளை டி. பி. மருந்து கண்டுபிடிப்பில் செலவழித்தேன் என்பதில் எனக்கு மிகவும் மகிழ்ச்சி.

Dr.Meenakshi Balaganesh is very adept in blending her scientific knowledge with her literary skills ever so dexterously that even a lay person like me find the article not only easily comrehensi le but quite interesting too.
GOD BLESS HER WITH THE REQUISITE ENERGY AND TIME ENABLING HER TO CONTINUE WITH HER PASSION TIRELESSLY.
LikeLike
நல்லதோர் அறிவியல் கட்டுரை. வாழ்த்துகள்.
LikeLike